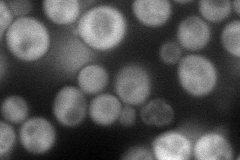
YBR057C
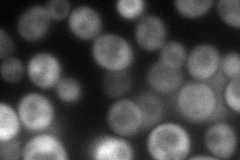
YBR057C
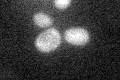
YBR057C

View description
Cytoplasmic protein essential for meiotic DNA replication and sporulation; interacts with Orc2p, which is a component of the origin recognition complex
Localization:
Intensity:
Fold change:
Significance:
-
C’ GFP library in SD

cytosol25.11 -
N' NOP1pr-GFP in SD
cytosol78.2512 -
N' TEF2pr-mCherry in SD
cytosol99.148 -
N' NATIVEpr-GFP in SD

cytosol32.3406 -
N' TEF2pr-VC and Cyto-VN in SD

#N/A0 -
C’ GFP library in SD+DTT

cytosolN/AN/ANo -
C’ GFP library in SD+H2O2

cytosol28.681.14No -
C’ GFP library in Starvation Media
cytosol29.971.19No -
C’ GFP library on the background of Pup2-DaMP

cytosol -
C’ GFP library on the background of CCT mutant

cytosol26.30051.04704No
